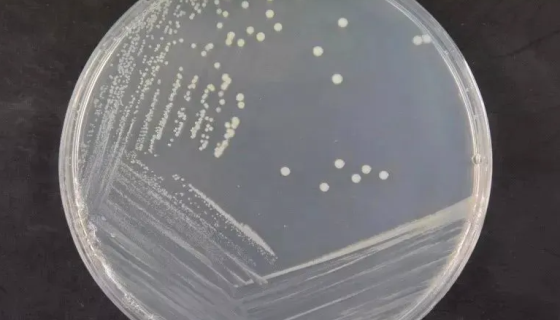
恶臭假单胞菌与产黄纤维假单胞菌联合使用：分解纤维素
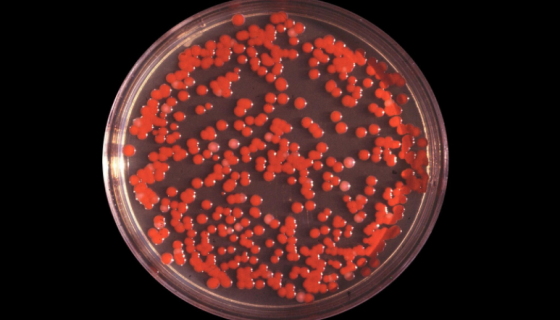
沙雷氏菌属的形态描述与生物学特性及菌株培养！
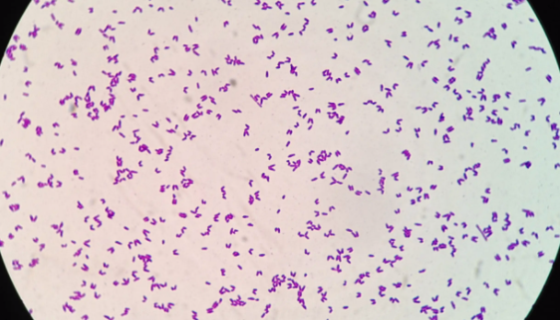
类谷糠乳杆菌的主要价值与培养条件及注意事项！
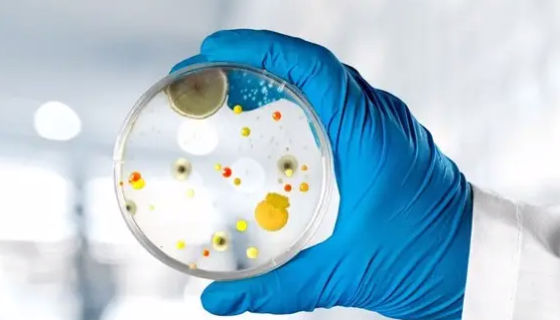
内蒙胎牛血清在细胞培养中的作用及应用！

恶臭假单胞菌与产黄纤维假单胞菌联合使用:分解纤维素
恶臭假单胞菌,革兰阴性杆菌,有些菌株为卵圆形,单端丛毛菌,运...
沙雷氏菌属的形态描述与生物学特性及菌株培养!
沙雷氏菌属,肠杆菌科的一个属。菌体直杆状,直径0.5~0.8...

肠炎沙门氏菌的构造和分类及主要区别!
肠炎沙门氏菌(Salmonellaenteritidis )...

小鼠肝炎病毒的抗原性与病原性及诊断与防制!
小鼠肝炎病毒(Mouse hepatitis virus)...

食用菌黑平菇的功效与作用及营养价值!
黑平菇,子实体中等至大型,寒冷季节子实体色调变深。菌盖直径5...
类谷糠乳杆菌的主要价值与培养条件及注意事项!
类谷糠乳杆菌是Lactobacillus属的微生物,原产地为...
内蒙胎牛血清在细胞培养中的作用及应用!
内蒙胎牛血清是由胎牛血浆去除纤维蛋白而形成的一种很复杂的混合...

神经干细胞的移植过程与途径及治疗机理!
神经干细胞(neural stem cell)是指存在于神经...
